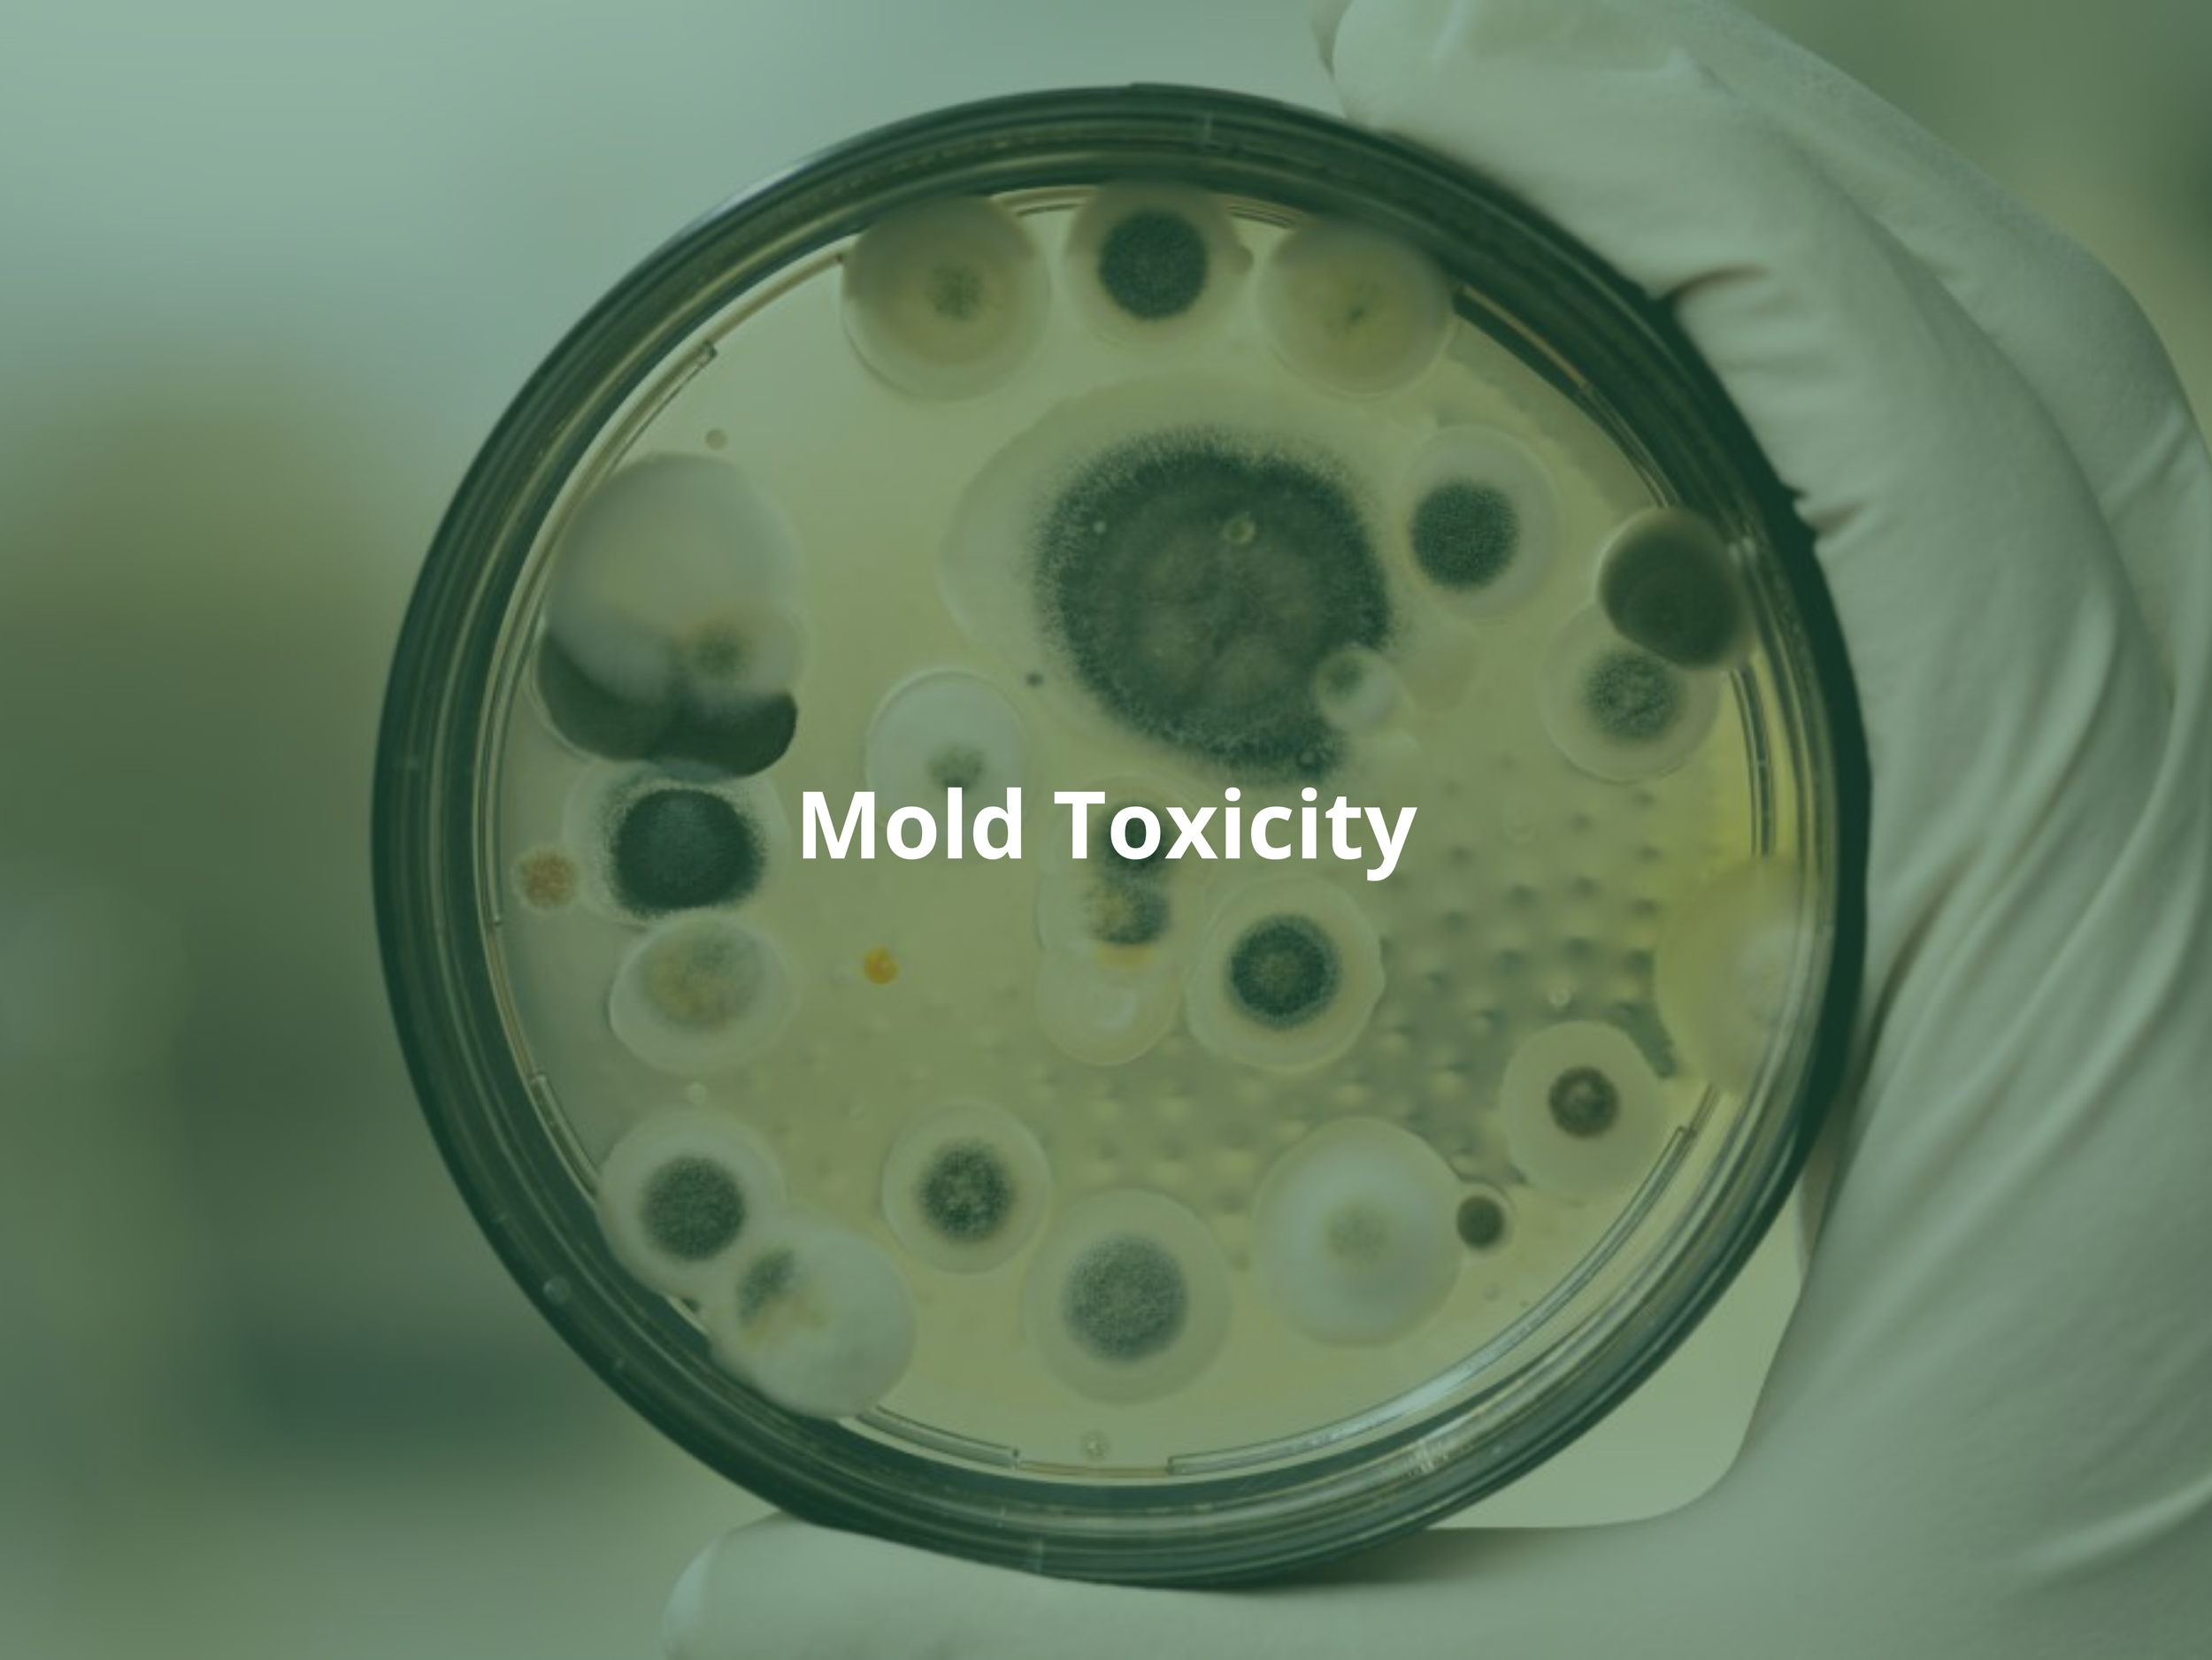
7.png

Functional Medicine
Don’t just treat symptoms.
At Optimal Health and Wellness, we believe that true health comes from understanding the whole person—not just treating symptoms. Our model integrates functional medicine, regenerative therapies, and conventional medical care to address the mind, body, and soul. Rather than simply reacting to illness or placing a temporary Band-Aid on symptoms, we work to identify and correct the root cause of disease.
We are passionate about developing personalized, science-driven treatment plans that help restore balance within the body. Our goal is to reinitiate, retrain, and optimize key biological systems—including metabolic health, immune function, hormonal pathways, neurological balance, and mental wellness. Through this approach, we empower our patients with long-term strategies, education, and tools that support lifelong health and vitality.

Frequently Asked Questions
-
By combining the above advanced diagnostic tools with targeted therapies, we are able to create precision treatment strategies tailored to each individual.
-
With functional medicine, Optimal Health and Wellness not only helps patients feel better today, but helps to build a foundation for lasting wellness, resilience, and optimal performance for years to come.
